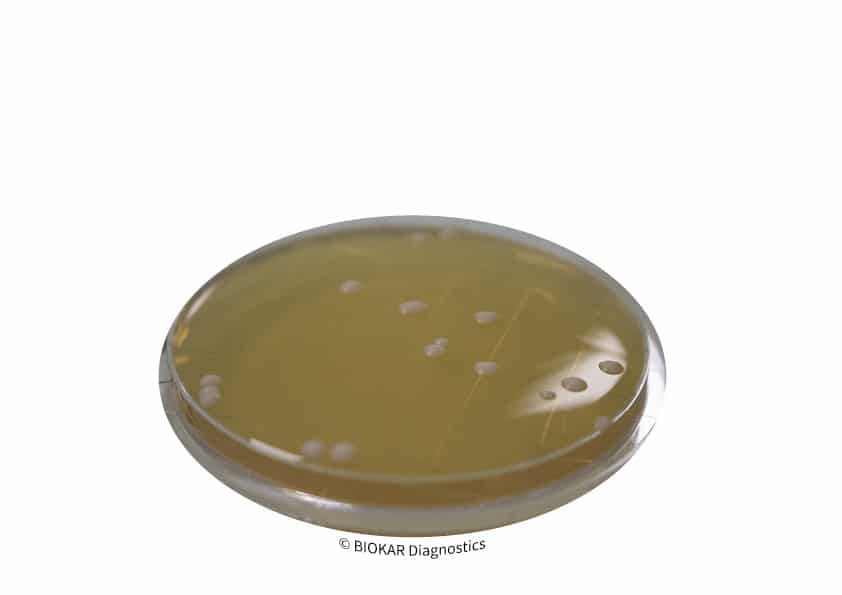
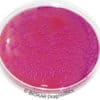
Contact Plates - VRBL + Neutralisers | Medical Supply Company

Contact Plates – Sabouraud Chloramphenicol (SDCA) + Neutralisers
Sabouraud Dextrose chloramphenicol Agar (SDCA) is used in contact plates for the isolation and the enumeration of yeasts and moulds, especially in areas that are contaminated with bacteria.
Packaging
Pre-poured plates:
20 plates Ø 65mm – BM21008

Reviews
There are no reviews yet.